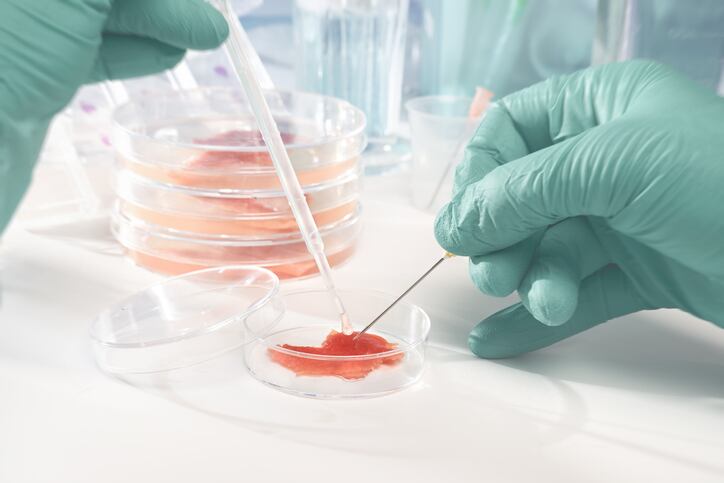

Stressed cows? Time to get the flute and sitar out, study reveals
Milking parlours may soon sound more like massage parlours after researchers found that exposing cows to Indian classical music reduced stress and had a ‘significant effect in milking time and milking speed’.